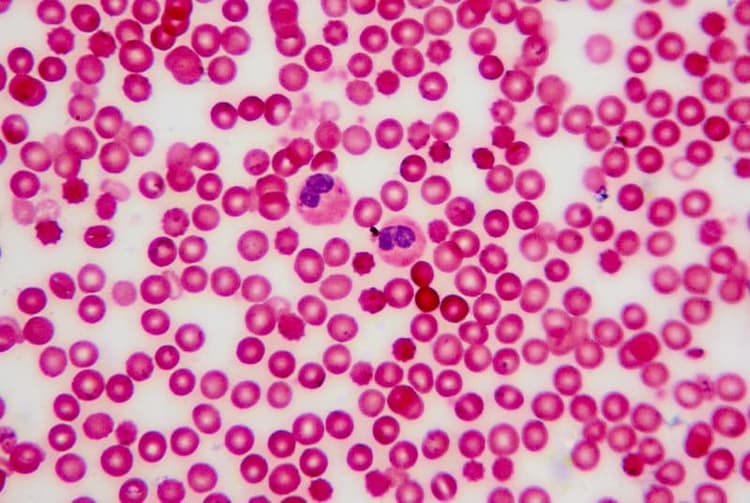
Microbioma nel sangue: un concetto innovativo
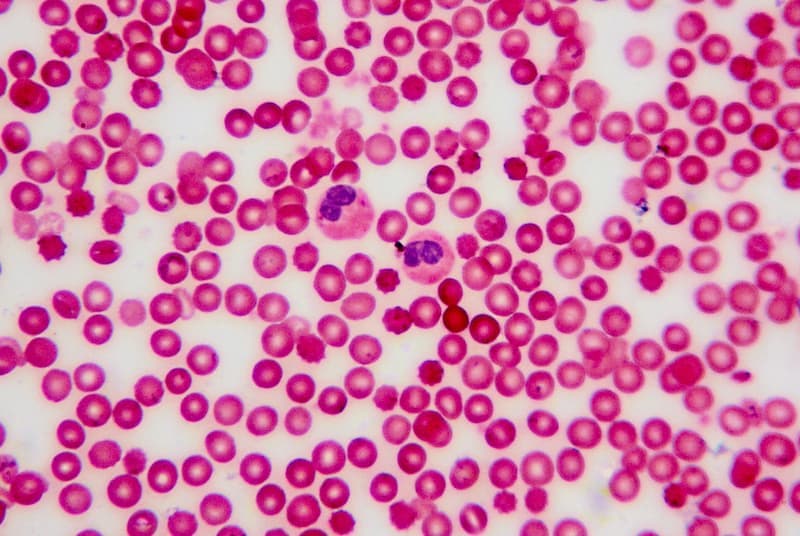
Microbioma nel sangue: un concetto innovativo

Animali da compagnia
Per il cane, impegnarsi nella masticazione è un’esigenza etologica. Pertanto, fornire masticativi adeguati non solo favorisce benessere e forma fisica, ma permette anche di contrastare un eventuale stato di stress dell’animale.
Uno dei nemici da combattere nelle otiti esterne è il biofilm: questa formazione ostacola l’azione dei farmaci e perpetua la patologia. La corretta esecuzione degli esami citologici e colturali permette di impostare una terapia efficace.
Il quarto webinar della serie relativa al gattino organizzata dal Gruppo Italiano Studio Pediatria Veterinaria, si è focalizzato sulle patologie dermatologiche più frequenti nel gattino.

Durante un incontro formativo si è parlato dell’uso di Ancaria nella gestione delle patologie palpebrali.

Grazie a Cogito Ergo Vet e a ICF DRN Nextmune Italia, si è tenuto un webinar dedicato all’antibioticoresistenza in dermatologia, seguito da circa 800 colleghi e tenuto dalla dott. ssa Chiara Noli. Durante l’evento è stato presentato anche il nuovo prodotto di ICF DRN Nextmune Italia: Peptivet soluzione otologica. L’antibioticoresistenza in medicina veterinaria L’AMR (Anti… Continua a leggere Peptivet soluzione otologica: una nuova aggiunta del catalogo ICF DRN Nextmune Italia nella lotta all’antibioticoresistenza
La Commissione UE ha presentato la roadmap per il settore agricolo comunitario al 2040, in cui si riconosce il ruolo centrale della zootecnia, e si sottolinea la necessità di promuovere sostenibilità ambientale, benessere animale e innovazione tecnologica, per rafforzare competitività e resilienza nelle aree rurali.
La letteratura sul meningioma e glioma del gatto è scarsa rispetto a quella relativa al cane; nonostante ciò, esiste la possibilità di diagnosticare e, ove possibile, trattare adeguatamente questi tumori.
Nel processo che conduce alla stampa non industriale di parti e componenti 3d utili allo svolgimento delle chirurgie ortopediche, tra medico veterinario e bioingegnere non si crea una sfida, bensì una stretta e solida collaborazione.
Le patologie virali del coniglio e della lepre con maggior significato clinico sono la malattia emorragica virale (MEV o Rabbit Hemorrhagic Disease, RHD) e la mixomatosi, sebbene anche altre, meno frequenti e meno problematiche, siano da conoscere.
Salute e benessere dei sauri pet si basano sulla prevenzione e la corretta gestione. Spettano al veterinario, quindi, sia diagnosi e terapia delle patologie, sia un’attività di sensibilizzazione dei proprietari verso i bisogni specifici di tali rettili.
Molto più frequente nel cane rispetto al gatto, la trombocitopenia immunomediata è stata oggetto di un recente consenso dell’American College of Veterinary Internal Medicine (ACVIM).
Spaziando dalla neurofarmacologia al dolore perioperatorio, le relazioni della prof.ssa Giorgia Della Rocca e del dott. Davide Gamba hanno illustrato diversi aspetti di algologia del gatto durante una giornata di studio organizzata da AIVPAfe.
La rottura tracheale intratoracica nel gatto è rara ma grave. Una tracheoscopia consente di confermare la diagnosi e valutare la gravità delle lesioni. Il trattamento d’elezione è chirurgico e dev’essere intrapreso non appena lo stato clinico dell’animale lo consente.
Continuano gli incontri del Gruppo Italiano Studio Pediatria Veterinaria dedicati all’alfabeto del gattino: la lettera C è stata incentrata sulle cardiopatie più comuni e gli strumenti diagnostici a disposizione del veterinario per una valutazione precoce.
Le prime visite devono costituire un’esperienza positiva per il gattino e anche per il proprietario. Accettazione e sala d’attesa rappresentano il primo impatto con la struttura, che dovrebbe garantire un approccio cat friendly.
Una nuova serie di incontri di aggiornamento professionale curata dal Gruppo Italiano Studio Pediatria Veterinaria si è aperta con la disamina delle peculiarità nutrizionali del gattino in età pediatrica, un paziente esigente.
Comprendere lo stato emozionale del cane fobico permette di migliorare la comunicazione tra i componenti del sistema famiglia interspecifico. Obiettivo dell’intervento riabilitativo è infatti fornire all’animale e al sistema famiglia nuove competenze per vivere la quotidianità.
In un contesto in cui le aspettative sociali e normative nei confronti della tutela degli animali sono in continua evoluzione, il DPCM 8 gennaio 2025 incentrato sulle manifestazioni equestri potrebbe rappresentare un passo significativo.
Un American Staffordshire terrier viene visitato per problemi alle unghie. Le diagnosi differenziali compatibili includono svariate patologie, ma le alterazioni esclusivamente alle unghie in tutti gli arti sono suggestive di SLO (onicodistrofia lupoide simmetrica).
Esistono diverse tipologie di alimenti per conigli, che vanno attentamente valutate per non incorrere in squilibri alimentari, all’origine di diverse patologie anche molto gravi. Il tutto nelle linee guida FEDIAF sull’alimentazione del coniglio da compagnia analizzate a cura dell’Ambulatorio veterinario Ghelfi-Nieddu.
In assenza di intervento chirurgico, per il dotto arterioso pervio di tipo sinistro-destro la prognosi è infausta. La gestione chirurgica può invece essere risolutiva, come descritto in questo caso di approccio endovascolare.
Tra le diverse affezioni che colpiscono le basse vie urinarie del cane e del gatto la cistite è uno dei problemi più frequenti, e se non trattata, può compromettere il benessere dell’animale e portare a complicanze più serie. Gli animali colpiti manifestano segni di disagio, difficoltà a urinare correttamente con tentativi infruttuosi e ripetuti e… Continua a leggere Cistite nel cane e nel gatto: CISTITINA di Buona Pet per coadiuvarne la risoluzione
Un caso di idronefrosi bilaterale in un gatto che ha comportato l’applicazione di subcutaneous ureteral bypass supporta la consapevolezza dell’importanza della diagnosi precoce di malattia renale al fine di valutare al meglio come poter intervenire per rallentarne la progressione.
Numerosi fattori influenzano positivamente o negativamente l’invecchiamento; tra questi si annovera anche la dieta. Come essa influisce sulla longevità e sul mantenimento della salute del cane in età avanzata?
Tra le opzioni per la gestione multimodale della dermatite atopica canina è indicata l’immunoterapia. Analizziamo uno studio di valutazione di un microarray molecolare multiplex per determinare le sensibilizzazioni IgE specifiche per gli allergeni.
In geriatria è necessario a livello preventivo attenzionare i cambiamenti che possono comparire in un animale che entra in una fase avanzata della vita, e per la gestione di tali pazienti adottare un approccio multidisciplinare. Il tutto al centro di un corso di aggiornamento dell’Ordine dei medici veterinari della Provincia di Cosenza.
Al XIX Congresso Nazionale UNISVET, nell’ambito della Masterclass di medicina interna, il dott. Federico Porporato (DVM, MRVCS, Dipl. ECVIM-CA Internal Medicine), ha affrontato il tema della colangite felina, patologia non infrequente nella clinica dei piccoli animali ma dalla gestione complessa.
La dilatazione-torsione gastrica è un’emergenza assoluta, perché la dilatazione di questo organo induce un triplice shock – ipovolemico, ipossico ed endotossiemico –, che può portare rapidamente alla morte del cane.
Tra le prime 10 città al mondo che hanno perso più giornate di gelo, tre sono italiane; il riscaldamento globale, con la minor durata del manto nevoso, favorisce il mantenimento delle popolazioni di vettori di malattie, e non solo.
Solitamente descritta come malattia cutanea paraneoplastica associata a timoma, per la dermatite esfoliativa felina, nel caso in cui non sia coinvolta tale neoplasia, la patogenesi non è ancora adeguatamente chiarita. Vediamo un caso clinico presentato dal dott. Fabbrini, DVM, Dipl. CES Dermatologia.
Le linee guida WSAVA e le recenti evidenze scientifiche esortano il medico veterinario a cambiare il proprio approccio al controllo della riproduzione nel cane e nel gatto: la gonadectomia non è più la soluzione indicata per tutti i pazienti, anzi, sono sempre più numerosi i dati sui suoi effetti collaterali. Ogni caso deve essere valutato singolarmente, tenendo conto di sesso, età, razza e stile di vita. L’opinione a riguardo della dott.ssa Pisu.
Nonostante si ritenga che i gatti siano animali solitari, recenti studi hanno osservato che vanno invece considerati esseri sociali, in grado di generare legami con i loro proprietari, e quindi è probabile che mostrino anche comportamenti e reazioni fisiologiche causati dalla loro assenza come l’ansia.
In un webinar organizzato da AIVPA si è parlato della gestione del paziente felino affetto da enteropatia cronica.
Nella specie felina l’obesità è una patologia ad alto tasso di insuccesso terapeutico e con una percentuale elevatissima di recidive; per la gestione del gatto obeso è fondamentale la compliance del caregiver.
Malattia dalle molteplici sfaccettature, inclusa la necessità di un’adeguata comunicazione con il proprietario, il diabete mellito del gatto pone svariate sfide al medico veterinario.
Un recente consensus ACVIM fornisce indicazioni per la terapia dello stato epilettico e delle crisi convulsive a grappolo nel cane e nel gatto, attraverso una classificazione delle procedure e l’analisi dei principali farmaci disponibili.
La cistite idiopatica felina può essere una sfida sia in termini di diagnosi sia di gestione delle cause e di trattamento, come ricordato nel webinar organizzato da AIVPA e tenuto dal dott. Stefano Bo.
La decisione di sterilizzare un animale dev’essere attentamente valutata, considerando per ciascuno specie, razza, sesso e stile di vita, nonché il profilo del proprietario (qualità della medicalizzazione, nozione di “proprietario responsabile”).

Il professionista ha a disposizione diversi strumenti diagnostici per individuare il dolore nel cavallo sportivo, anche quando non è evidente. Sono particolarmente utili alcuni cambiamenti comportamentali e le informazioni ottenute dalle persone che entrano in contatto con il cavallo quotidianamente.
La prevalenza dei parassiti intestinali nei cani dell’Europa occidentale è elevata. L’identificazione delle loro uova mediante coproscopia richiede alcune accortezze, il test antigenico appare invece interessante per lo screening individuale.
A un evento formativo dell’Ordine della provincia di Pesaro e Urbino si è parlato di endocrinologia del cane e del gatto con il dott. Corsini.
Le cellule mesenchimali stromali rappresentano una frontiera innovativa nel campo della medicina rigenerativa veterinaria e, sebbene siano ancora necessarie ulteriori ricerche per affrontare le sfide tecniche e regolatorie, il loro potenziale terapeutico è innegabile. Tuttavia, è necessario prestare molta attenzione alle interazioni on i farmaci tradizionali attualmente note.
Le prestazioni sportive richiedono il funzionamento ottimale di tutti i sistemi fisiologici coinvolti. Le condizioni mediche subcliniche possono influenzare le prestazioni di un cavallo sportivo. Un check-up medico completo all’inizio della stagione, che comprenda un esame clinico ed eventualmente un test da sforzo, consente di valutare lo stato di salute del cavallo e il livello di allenamento, di raccogliere i valori normali individuali (parametri emato-biochimici) e di mettere in atto misure preventive prima di intraprendere una fase di allenamento più intensa. Gli esami di follow-up assicurano che l’allenamento, il trasporto e le competizioni non alterino lo stato di salute del cavallo, in modo che possa dare il meglio di sé per raggiungere l’obiettivo sportivo. Gli strumenti connessi da remoto possono aiutare i veterinari a monitorare le condizioni del cavallo, a condizione che abbiano la formazione necessaria e il tempo per analizzare i dati.
I rettili sono serbatoi di una vasta gamma di patogeni, tra cui virus, batteri, protozoi, elminti, pentastomidi e specie parassite di artropodi, alcuni dei quali sono agenti di zoonosi, e costituiscono un problema di salute pubblica.
Dopo aver passato in rassegna le malattie dermatologiche di origine infettiva che colpiscono i roditori, focalizziamo ora l’attenzione sulle dermatosi di origine ambientale, endocrina o tumorale. In particolare, la gestione delle dermatosi ambientali richiede una conoscenza precisa dei bisogni fisiologici di ciascuna specie di roditore.

Le dermatosi nei roditori da compagnia sono molto frequenti: ogni dieci visite di questi animali, da 3 a 5 casi sono dovuti a queste forme patologiche. Per indagarle, l’iter diagnostico è parzialmente sovrapponibile a quello dei carnivori domestici, ma risulta comunque più difficile date le ridotte dimensioni di queste specie.
Quali sono i segni clinici e gli esami complementari che portano alla definizione di soggetto cardiopatico e quali sono le insidie da affrontare?
I prodotti terapeutici derivanti da tessuti ricchi di cellule mesenchimali stromali e la terapia cellulare nelle malattie neurologiche degli animali sono stati i temi prevalenti della sesta parte del percorso formativo organizzato dal GISMVet.
L’impiego delle cellule mesenchimali stromali risulta fruttuoso in alcune patologie renali, epatiche e riproduttive come testimoniano i casi clinici riportati durante il quinto incontro del percorso formativo organizzato da GISMVet.
Diversi studi mostrano che gengivostomatite cronica del gatto, cheratite nel cavallo ed enteropatie croniche nel cane traggono beneficio dal trattamento con cellule mesenchimali stromali, come illustrato nel quarto webinar organizzato da GISMVet.
La terapia a base di MSC (cellule mesenchimali stromali) può avere un effetto positivo e dev’essere tenuta in considerazione, ma il veterinario deve conoscere la gestione del trasporto e la conservazione di queste entità viventi, nonché le modalità di applicazione e i dosaggi, stante la collaborazione continua tra clinico e laboratorista.
Le cellule mesenchimali stromali (MSC) interagiscono con il sistema immunitario per il ripristino dell’architettura tissutale e la risoluzione dell’infiammazione. Il loro utilizzo presenta aspetti normativi, in quanto farmaci cellulari. Tutto questo nel secondo incontro sull’argomento organizzato dal GISMVet.
Uno degli argomenti più promettenti
per il futuro della Medicina Veterinaria
è rappresentato dalle cellule mesenchimali
stromali (MSC) che ha implicazioni
potenzialmente rivoluzionarie, a patto
di conoscerlo bene. Il GISMVet ha promosso un corso di approfondimento
il cui primo incontro è stato incentrato proprio sul capire cosa sono e come funzionano le MSC.
La collaborazione tra Medicina Veterinaria e Umana si fa sempre più stretta e fruttuosa. Un esempio? Il registro di tumori animali, uno strumento utile come indicatore epidemiologico, ma capace di apportare nuove spunti in ambito umano grazie a specie sentinella come il gatto.
I concetti chiave per lo studio radiografico dell’apparato gastrointestinale sono stati spiegati durante un seminario che si è focalizzato sulla lettura delle immagini radiografiche in corso di patologie da trattare con urgenza.
Durante un evento di aggiornamento professionale organizzato da Forza10, i
relatori, esperti del settore, hanno puntato l’attenzione sull’approccio pratico
alle patologie gastrointestinali e sull’utilizzo della dieta in terapia.
Uno studio italo-spagnolo ha indagato l’escrezione urinaria di podocina e nefrina come marker precoci di danno renale nei cani con leishmaniosi.
Il dott. Ghibaudo ha realizzato una panoramiche sulle principali patologie dell’orecchio del gatto al congresso nazionale AIVPAFe.
I tumori oculari felini sono una evenienza non così infrequente nella pratica clinica. Possono essere classificati secondo la localizzazione anatomica e in primari e secondari. La relazione della dott.ssa Crasta al congresso nazionale AIVPAFe ha riassunto i principali punti salienti a riguardo.
Il gatto è un cacciatore solitario, con un profilo comportamentale a sé stante. Anche per quanto riguarda l’alimentazione, vi sono molte particolarità da tenere presenti per non indurre la manifestazione di alterazioni comportamentali. Se ne è parlato nel corso
di un evento promosso da AIVPA.
I principi chiave, corredati da un esempio pratico, per formulare una dieta equilibrata per il cavallo anziano.
In presenza di otite esterna è sempre opportuno effettuare un esame
dermatologico approfondito. Nel decorso terapeutico la compliance del proprietario può essere ottenuta ricorrendo a farmaci di facile somministrazione che assicurino la prosecuzione della terapia senza incorrere nel rischio di sovra o sottodosaggio del principio attivo.

Con il progetto ”Virbac on the road: la svolta nel trattamento dell’otite” Virbac ha organizzato degli incontri in tutta Italia per parlare di otite esterna e nuove strategie terapeutiche grazie all’intervento di un relatore di alto profilo come il dott. Giovanni Ghibaudo.
Tra le tecniche di anestesia locoregionale, l’applicazione del catetere epidurale nel cavallo può mostrare numerosi vantaggi come strategia analgesica multimodale. Tuttavia è necessario essere procedere con rigore e cautela sia nella procedura sia nell’impiego delle molecole anestetiche-analgesiche.
Nel paziente volatile, già da un paio di gocce di sangue si possono ottenere
svariate informazioni, preziose per avallare o indirizzare una diagnosi e quindi impostare una terapia tempestiva e adeguata ad ogni specie.
Un breve ma esaustivo vademecum sulle norme da rispettare nei viaggi con i pet in Paesi europei ed Extraeuropei.
Le zoonosi trasmesse dai NAC sono molte e spesso il rischio di trasmissione viene sottovalutato dal proprietario e del medico veterinario stesso.
Analogamente a quanto avviene per i carnivori domestici, anche nella cavia peruviana la gestione a lungo termine della riproduzione prevede la sterilizzazione.
Tuttavia, nel caso della cavia, molto sensibile allo stress operatorio, il rapporto
rischio/beneficio dell’intervento chirurgico è meno favorevole rispetto ad altre specie, soprattutto per la femmina. È possibile considerare anche delle alternative, come la sterilizzazione chimica.
Le patologie epatiche dei rettili possono essere particolarmente insidiose da riconoscere. Tra patologie infiammatorie, metaboliche, neoplastiche, parassitarie e micotiche, è facile commettere degli errori. In questi casi è imperativo conoscere nel dettaglio le caratteristiche e suscettibilità di ogni specie di rettile e gli strumenti diagnostici più adatti.

L’iter diagnostico in caso di una malattia che si esprime con overgrooming comprende non solo la visita dermatologica ma anche un’anamnesi minuziosa e la valutazione all’esame clinico dei segni di un possibile problema neurologico.
Posizionare nel modo corretto gli elettrodi, impostare i parametri della carta millimetrata e saper interpretare il tracciato ECG nel modo corretto sono i passi fondamentali per la diagnosi delle aritmie nel cavallo.
L’idramnios e l’idroallantoide sono due rare condizioni che comportano un eccessivo accumulo di liquido amniotico o allantoideo. L’eziologia e la fisiopatologia dell’idropisia degli involucri fetali
rimangono poco conosciute e il feto generalmente non è vitale. In questo articolo si descrive un caso clinico di idramnios che ha comportato un grande carico di responsabilità del proprietario.
Numerosi preconcetti continuano a influenzare alcune pratiche in campo alimentare. Sebbene non sia facile confutare i dati empirici, è legittimo esprimere riserve sulle giustificazioni “scientifiche”
che li accompagnano nella grande maggioranza dei casi.
La PPID è una malattia comune nei cavalli anziani. Sebbene attualmente non sia curabile, la malattia e le sue complicazioni, tra cui la laminite, possono essere controllate se individuate precocemente. Un approccio diagnostico rigoroso che includa il contesto clinico del cavallo, unito a un’interpretazione ragionata degli esami diagnostici, è necessario per formulare correttamente una diagnosi di PPID. Una volta formulata la diagnosi di PPID, e necessario prendere in considerazione una gestione globale del cavallo anziano.
La West Nile Disease è una patologia zoonisca dalle grandi ripercussioni sulla sanità pubblica a causa di forme gravi anche mortali nell’uomo. Essa è strettamente legata al ciclo dei vettori, le zanzare, che fanno da vettori ponte tra gli uccelli e specie recettive ma a fondo cieco come uomo e cavallo.

Uno studio retrospettivo francese ha indagato i principali effetti avversi dovuti a farmaci impiegati nel trattamento della dermatite atopica del cane e del gatto: lokivetmab, oclacitinib e ciclosporina.
La terapia multimodale della dermatite atopica nel cane e nel gatto necessita dell’uso corretto di farmaci dalla comprovata efficacia, come corticosteroidi, ciclosporina, oclacitinib e lokivetmab, bilanciando pro e contro di ognuno.
La dermatite atopica è una patologia multifattoriale di grande importanza nella clinica dei piccoli animali. Tra gli aspetti più studiati e utili per comprendere e impostare una terapia appropriata vi è l’immonopatogenesi.
Una panoramica sulla peritonite infettiva felina (FIP) con le più aggiornate conoscenze a riguardo.
Le infezioni nosocomiali possono rivelarsi un grande problema per la sanità animale e pubblica. Conoscerne le modalità di diffusione e gli agenti eziologici è di fondamentale importanza per il clinico dei piccoli animali.
Il dott. Vitale del CReNaL riassume le principali tematiche legate alla sempre più ampia diffusione della leishmaniosi in Italia con particolare attenzione agli aspetti di One Health.
Le principali patologie e problematiche gestionali dei pesci ornamentali che deve affrontare il medico veterinario, e l’importanza di un buon rapporto di fiducia con il proprietario.
Uno sguardo alle cistiti, pielonefriti e prostatiti nel cane e nel gatto: dalla diagnosi al trattamento medico.
Consigli sulla gestione degli animali ospedalizzati per prevenire la sindrome da rialimentazione, un’evenienza tutt’altro che remota se non affrontata adeguatamente.
Diagnosi e terapia delle diverse tipologie di eritrocitosi nel cane e nel gatto.
La prof.ssa Paola Fossati chiarisce le principali questioni legali inerenti all’eutanasia in un incontro promosso dall’ADVM.
Le principali caratteristiche benefiche non-diuretiche della torasemide in ambito cardiologico: anti-aldosterone, anti-fibrosi, anti-ipertensione.
La diagnosi precoce è sempre più un imperativo in nefrologia. In questo articolo il dott. Claudio Brovida ha illustrato alcuni nuovi marcatori biologici che possono aiutare nella diagnostica differenziale in corso di nefropatia.
I principi di diagnostica e di trattamento dei versamenti cavitari nel cane e nel gatto, e i vantaggi dell’uso della neutraceutica nella gestione post-chirurgica del paziente in al centro di un incontro con il dott. Montinaro, il dott. Bussadori e il prof. Gramenzi.
Uno studio britannico ha evidenziato le caratteristiche del linfoma nel gatto giovane e pediatrico e la risposta alla terapia.
Consigli su diagnosi e terapia delle principali affezione che riguardano il sistema biliare del cane e del gatto dal congresso AFVAC 2022.
Caso clinico con una correzione chirurgica di un Blouldogue francese con sindrome brachicefalica. Una serie di tecniche consente di facilitare il passaggio dell’aria nel rinofaringe. Talvolta è necessaria l’ossigenoterapia durante le prime 24 ore dopo l’intervento, ma la prognosi a lungo termine è buona.
Le principali caratteristiche dei tumori gastrici e intestinali del cane e del gatto prese in esame dal dott. Romanelli, in un incontro organizzato da UNISVET.
Le principali caratteristiche dei tumori orali del cane e del gatto prese in esame dal dott. Romanelli, in un incontro organizzato da UNISVET.
Grazie a uno studio italo-americano è stato possibile provare la presenza di un vero microbioma nel sangue di cani, con notevoli differenze in caso di soggetti sani o con patologie gastroenteriche croniche, a riprova del cosiddetto leaky gut.
Il soffio nel gatto può avere innumerevoli significati e cause, ma non deve essere mai sottovalutato, soprattutto dai proprietari.